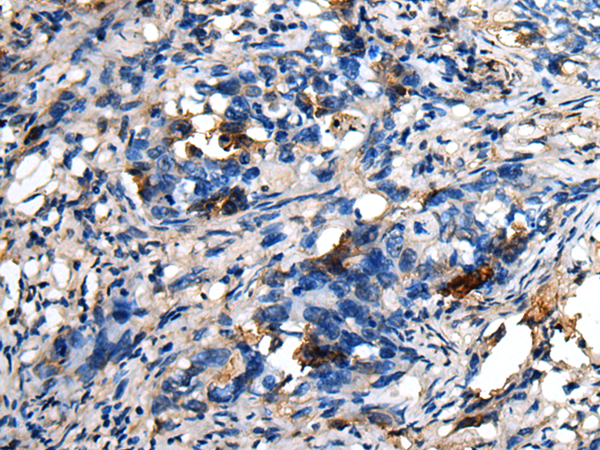
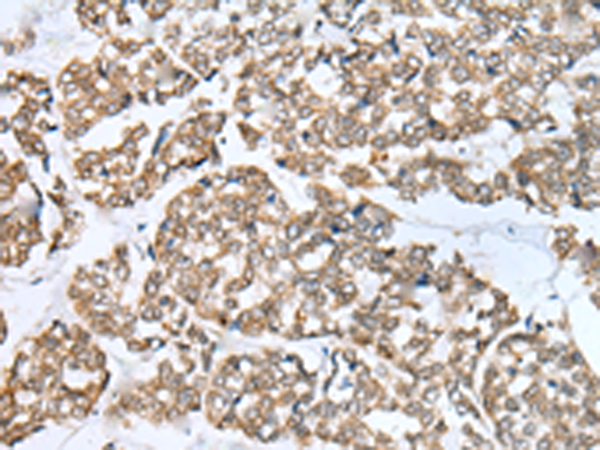
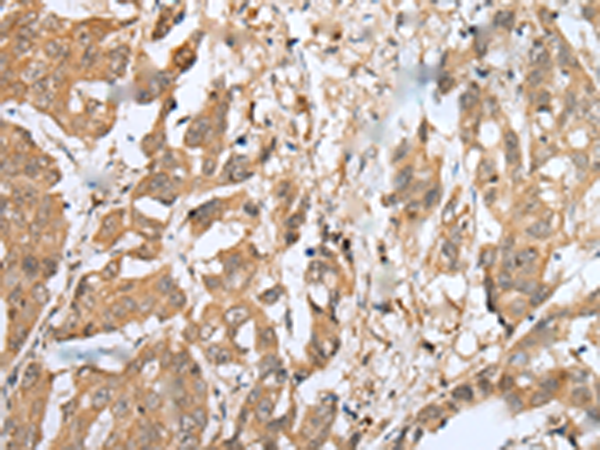
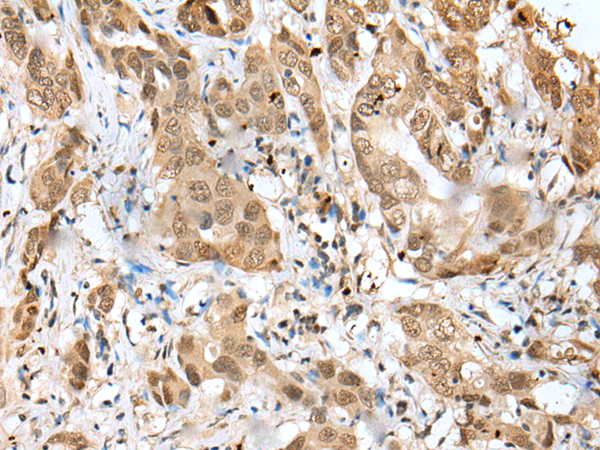

-
分类: 科研抗体货号: P09175别名: EF7; OIT1应用: WB,IHC反应种属: Human
-
分类: 科研抗体货号: P09153别名: DRP; DRP1; SMAP-3应用: WB,IHC反应种属: Human, Mouse
-
分类: 科研抗体货号: P09174别名: KOX15; HKR-T1; ZNF422; Zfp422应用: WB,IHC反应种属: Human, Mouse, Rat
-
分类: 科研抗体货号: P09152别名: CLP; MLP; CRP3; LMO4; CMD1M; CMH12应用: WB,IHC反应种属: Human, Mouse, Rat
-
分类: 科研抗体货号: P09173别名: SLD5应用: WB,IHC反应种属: Human, Mouse, Rat
-
分类: 科研抗体货号: P09151别名: SAP-3; GM2-AP应用: WB,IHC反应种属: Human, Mouse
-
分类: 科研抗体货号: P09172别名: MDG1; ERdj4; MDG-1; MST049; MSTP049应用: IHC反应种属: Human, Mouse, Rat
-
分类: 科研抗体货号: P09181别名: ZNF313; PSORS12应用: IHC反应种属: Human, Mouse, Rat
-
分类: 科研抗体货号: P09180别名: p28ING5应用: WB,IHC反应种属: Human, Mouse
-
分类: 科研抗体货号: P09170别名:应用: IHC反应种属: Human

鄂公网安备42018502007531号
鄂公网安备42018502007531号

